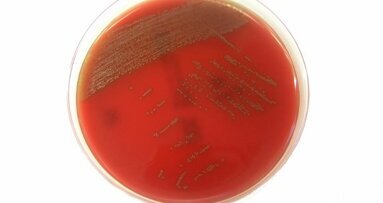
Une bactérie sur les muqueuses buccales pourrait provoquer des maladies graves si elle passe dans le sang

Entre 1997 et 2009, la proportion d’obèses dans la population française adulte est passée de 6,5 % à 14,5 %, selon une récente enquête Obépi-Roche. Cette hausse continue fait de l’obésité un problème de santé publique majeur, en raison des risques engendrés et de son impact sur les comptes de la Sécu.
La commission des affaires sociales de l’Assemblée nationale, lors de la discussion du projet de loi 2010 de financement de la Sécurité sociale, en octobre 2009, avait adopté un amendement instituant une taxe sur les sodas sucrés, de 3 à 6 centimes par litre dont le texte n’a pas été adopté en séance. Certains spécialistes sont pourtant persuadés du bien-fondé de cette mesure. Le député Marie-Anne Montchamp (UMP, Val-de-Marne), à l’origine de l’amendement rejeté en octobre 2009 a déclaré qu’elle allait re-proposer cette taxe allant « dans le sens de l’histoire ».
Cologne, Allemagne : À l'occasion du congrès de l'IDS de cette année, l'Association des dépôts dentaires européens ...
Suite à une première édition en octobre 2016, des conférenciers de renommée mondiale participeront à #ColgateTalks...
PARIS, France : « L’idée de créer un impôt sur la maladie, c’est une blague ? », tel est le slogan de la ...
PARIS, France : « L’idée de créer un impôt sur la maladie, c’est une blague ? », tel est le slogan de la ...
La loi « Hôpital, patients, santé et territoires » (HPST) imposerait aux chirurgiens-dentistes d’informer les patients sur le...
LONDRES, Royaume-Uni: Manger des fruits comme les pommes pourrait faire jusqu'à quatre fois plus de dommages aux dents que les boissons gazeuses, ont...
ZURICH, Suisse : La bactérie, identifiée par des chercheurs de l’Institut de Microbiologie Médicale de Zurich, a ...
Toute reconstitution dentaire vise à rétablir le rôle et le caractère naturel du système stomatognathique et en ...
AARHUS, Danemark: Alors que l’intégration de l’intelligence artificielle (IA) dans le secteur dentaire continue de s’accélérer, un consensus semble...
BRUXELLES, Belgique : La Commission européenne a annoncé une révision de la législation qui régit les appareils ...
Webinaire en direct
mar. le 23 juin 2026
à 19h00 (CET) Paris
Webinaire en direct
mar. le 23 juin 2026
à 21h00 (CET) Paris
Webinaire en direct
mer. le 24 juin 2026
à 14h00 (CET) Paris
Webinaire en direct
mer. le 24 juin 2026
à 17h00 (CET) Paris
Webinaire en direct
mer. le 24 juin 2026
à 18h30 (CET) Paris
Dr. med. dent. Britta Hahn
Webinaire en direct
jeu. le 25 juin 2026
à 20h00 (CET) Paris
Dr. Hatem Algraffee, Cat Edney
Webinaire en direct
mar. le 30 juin 2026
à 17h00 (CET) Paris



 Autriche / Österreich
Autriche / Österreich
 Bosnie Herzégovine / Босна и Херцеговина
Bosnie Herzégovine / Босна и Херцеговина
 Bulgarie / България
Bulgarie / България
 Croatie / Hrvatska
Croatie / Hrvatska
 République tchèque et Slovaquie / Česká republika & Slovensko
République tchèque et Slovaquie / Česká republika & Slovensko
 France / France
France / France
 Allemagne / Deutschland
Allemagne / Deutschland
 Grèce / ΕΛΛΑΔΑ
Grèce / ΕΛΛΑΔΑ
 Hongrie / Hungary
Hongrie / Hungary
 Italie / Italia
Italie / Italia
 Pays-Bas / Nederland
Pays-Bas / Nederland
 Nordique / Nordic
Nordique / Nordic
 Pologne / Polska
Pologne / Polska
 Portugal / Portugal
Portugal / Portugal
 Roumanie & Moldavie / România & Moldova
Roumanie & Moldavie / România & Moldova
 Slovénie / Slovenija
Slovénie / Slovenija
 Serbie et Monténégro / Србија и Црна Гора
Serbie et Monténégro / Србија и Црна Гора
 Espagne / España
Espagne / España
 Suisse / Schweiz
Suisse / Schweiz
 Turquie / Türkiye
Turquie / Türkiye
 Royaume-Uni et Irlande / UK & Ireland
Royaume-Uni et Irlande / UK & Ireland
 International / International
International / International
 Brésil / Brasil
Brésil / Brasil
 Canada / Canada
Canada / Canada
 Amérique latine / Latinoamérica
Amérique latine / Latinoamérica
 États-Unis / USA
États-Unis / USA
 Chine / 中国
Chine / 中国
 Inde / भारत गणराज्य
Inde / भारत गणराज्य
 Pakistan / Pākistān
Pakistan / Pākistān
 Vietnam / Việt Nam
Vietnam / Việt Nam
 ANASE / ASEAN
ANASE / ASEAN
 Israël / מְדִינַת יִשְׂרָאֵל
Israël / מְדִינַת יִשְׂרָאֵל
 Algérie, Maroc et Tunisie / الجزائر والمغرب وتونس
Algérie, Maroc et Tunisie / الجزائر والمغرب وتونس
 Moyen-Orient / Middle East
Moyen-Orient / Middle East

To post a reply please login or register